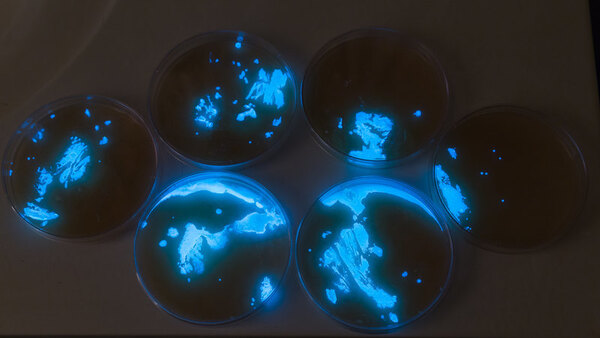

Рубрикатор
- Введение: что такое биоарт
- Жизнь как медиум: работа с живым материалом
- История биоарта
- Кейсы и смыслы
- Заключение
- Источники
Что такое биоарт
В последние десятилетия в современном искусстве появилось направление, в котором художники работают не с традиционными медиа — изображением, звуком или цифровыми технологиями, — а с живыми организмами и биологическими процессами. Это направление называют биоартом. В отличие от научной визуализации, где биология служит объектом исследования, или эко-арта, где природные материалы используются как символ, биоарт делает шаг дальше: жизнь становится не темой, а самим художественным материалом.


Работа художников с живыми материалами и биотехнологическим оборудованием. Био-художественная лаборатория SVA
Биоарт возникает на пересечении искусства, науки и технологий. Художники сотрудничают с биологами, работают в лабораториях, используют методы генной инженерии, культивирования клеток, микробиологии и биолюминесценции. Такой подход меняет привычное представление о материальности произведения: вместо стабильного объекта на первый план выходит процесс роста, изменения и реакции живых систем. Произведение становится нестабильным, развивающимся, иногда — самоуправляемым.


Био-художественная лаборатория SVA: пространство пересечения науки и искусства
Обращение к жизни как медиуму особенно актуально сегодня, в эпоху биотехнологических прорывов, экологических кризисов и пересмотра границ между человеком, природой и технологиями. Биоарт поднимает вопросы, которые стоят в центре внимания общества: — где проходит граница между научным экспериментом и художественным жестом? — допустимо ли манипулировать живыми существами ради искусства? — как меняется человек, когда он получает возможность создавать или модифицировать жизнь?


Органические формы как художественный материал в биоарте, BioArt Laboratories, Эйндховен (Нидерланды)
В рамках этого исследования тема «Биоарт: жизнь как медиум» рассматривается через анализ ключевой идеи — использования живого материала как основного художественного инструмента. Такие практики позволяют увидеть, как современное искусство исследует биологию не только эстетически, но и философски, превращая жизненные процессы в способ высказывания.
Жизнь как медиум: работа с живым материалом
Одним из принципиально новых аспектов биоарта является использование живых организмов и биологических процессов в качестве самостоятельного художественного медиума.


Клеточные структуры: визуализация живого материала


Микромир бактерий: визуализация структуры и динамики живого материала
Биолюминесцентные бактерии под микроскопом: живой материал как медиум современного искусства
В отличие от традиционных материалов искусства — краски, камня, фотографии или цифрового изображения — здесь материалом становятся клетки, бактерии, грибницы, растительные ткани, биолюминесцентные микроорганизмы и другие формы живого. Художник работает не с изображением жизни, а с самой жизнью, позволяя ей формировать, изменять и дополнять произведение.
Рост бактерий в чашках Петри
Живые материалы обладают особенностями, которые радикально меняют художественный подход. Они растут, изменяются во времени, реагируют на внешние условия, могут болеть, гибнуть или, напротив, разрастаться. В такой работе художник не контролирует процесс полностью — он создаёт условия, направляет развитие, но оставляет пространство для автономного поведения системы. Это превращает произведение в событие, процесс, среду, а не в фиксированный объект.


Керамическая ваза с глазурью на основе рыбных костей, BioArt Laboratories, Эйндховен (Нидерланды)
Использование живых материалов открывает художникам возможность исследовать фундаментальные вопросы: что такое «жизнь» в контексте искусства? Может ли биологический процесс быть художественной формой? Как меняются представления об авторстве, если часть работы создаётся не человеком, а организмом?
Светящаяся биолюминесцентная петуния: искусство генной инженерии и живой свет. Компания Light Bio
Через живые ткани, микроорганизмы и природные структуры художники создают не только визуальные образы, но и новые отношения между человеком и природой, между технологией и биологией. Живой материал становится инструментом художественного высказывания, меняя саму природу произведения и расширяя границы современной художественной практики.
История биоарта
Этап 1. Ранние эксперименты с живым материалом (конец XX века)
Работы испанской художницы Maria Peñil Cobo, выполненные на чашках Петри с помощью бактерий.
В этот период художники впервые начинают работать с живыми клетками, тканями и микроорганизмами как с художественным материалом. Основное внимание сосредоточено не на технологиях, а на самом факте того, что живые процессы могут становиться материалом для искусства. Работы этого этапа напоминают лабораторные наблюдения: художники изучают, как живые структуры растут, изменяются и формируют непредсказуемые визуальные эффекты. Важным становится сам процесс развития — то, что материал живёт и развивается независимо от художника.
Этап 2. Формирование биоарта как направления (1990-е — 2000-е)
SymbioticA — «Victimless Leather» (2004)
В 1990-е биотехнологии становятся доступнее, и художники активно входят в научные лаборатории. Этот период характеризуется переходом от символического использования биологии к работе с реальными биотехнологическими процессами, которые разворачиваются «вживую» на глазах зрителя. В художественных проектах появляются генетически модифицированные растения, живые ткани, клетки, которые необходимо поддерживать, кормить, освещать. Экспонаты становятся живыми системами, требующими ухода и постоянного взаимодействия.
Этап 3. Современный биоарт (2010-е — настоящее время)
Anicka Yi — «Biologizing the Machine»
Современный биоарт выходит за пределы лабораторий и обращается к теме отношений человека с другими видами. Художники исследуют экологические процессы, создают микросистемы, в которых растения, микроорганизмы и технологии взаимодействуют между собой. Произведения всё чаще напоминают живые экосистемы: они растут, реагируют на свет и влажность, изменяются со временем и иногда даже разрушаются естественным образом. Художник уже не стремится полностью контролировать процесс, а скорее создает условия и наблюдает развитие жизни внутри этих рамок.
Кейсы и смыслы
В этом разделе рассмотрены три знаковых проекта, каждый из которых по-разному раскрывает использование живых материалов как художественного медиума. Эти работы стали поворотными точками в развитии биоарта и ясно демонстрируют, как живые системы способны формировать новые эстетические, этические и философские смыслы в искусстве.
Кейс 1. Eduardo Kac — GFP Bunny (2000)

Материал: живой организм — трансгенный кролик

Эдуардо Кац и кролик Альба

Технология: генетическая модификация (введение гена зелёного флуоресцентного белка медузы)

Светящиеся медузы
Проект Эдуардо Каца стал одной из самых известных и обсуждаемых работ биоарта. Художник создал кролика по кличке Альба, в чьё ДНК был встроен ген GFP — белок, который заставляет организм светиться зелёным под ультрафиолетом.
Флуоресцентный кролик, Эдуардо Кац, 2000 г.
Эта работа не столько о генетике, сколько об отношениях между человеком и другими видами, о возможности присваивать себе право изменять живые существа. Кац утверждал, что его цель — «гуманизировать биотехнологии», показать, что генетическая манипуляция становится частью повседневности. Однако реакция общества продемонстрировала обратное: проект вызвал масштабную дискуссию о границах вмешательства в жизнь и о том, можно ли считать такие действия искусством.
Кейс 2. Tissue Culture & Art Project — Victimless Leather (2004–2008)

Материал: живые клетки млекопитающих, выращенные в форме миниатюрной «кожаной» куртки

Скульптура из клеток, созданных методом тканевой инженерии, пластинированная Жилем Дезрайсом в 2010 году

Технология: клеточные культуры, биореакторы, тканевая инженерия

Биореактор
Австралийский дуэт The Tissue Culture & Art Project (Орён Кац и Ионат Зур) создал объект, напоминающий крохотную кожаную куртку — но эта «кожа» была выращена не на животном, а в лаборатории. Клетки росли на биополимерном каркасе, формируя самостоятельный живой объект.
Кожаная куртка, выращенная в биореакторе
Проект исследует идею «безжертвенной кожи» — материала, который не требует убоя животного. Однако в ходе одного из показов кураторы были вынуждены отключить биореактор, в результате чего объект погиб. Этот момент стал частью дискуссии: если произведение живое, кто несёт ответственность за его жизнь и смерть?
Кейс 3. Teresa van Dongen — Bioluminescent Lamp (2014–наст.)
Материал: живые биолюминесцентные бактерии Vibrio fischeri

Биолюминесцентные бактерии

Технология: морские бактерии, поддерживающие свечение через биореакцию кислорода

Биолюминесценция
Работы Терезы ван Донген демонстрируют, как биолюминесценция может стать альтернативным источником света и одновременно художественным объектом. Её лампы основаны на бактериях, которые светятся в темноте при движении или поступлении кислорода. Художница создаёт закрытые сосуды, где живые организмы производят мягкое голубое свечение, создавая образ «живого света».
Биолюминесцентная лампа
Этот проект соединяет эстетику, экологию и биотехнологии: свет полностью «натуральный», без электричества, но поддержание бактерий требует постоянной заботы. Произведение становится системой, которая нуждается в уходе — как растение или животное.
Заключение
Биоарт занимает особое место в современном искусстве, поскольку использует живые материалы как самостоятельный художественный медиум. Работа с клетками, бактериями, тканями и экосистемами не только расширяет возможности художественного языка, но и ставит перед зрителем и обществом новые вопросы, которые выходят за рамки эстетики. Живые системы делают произведение нестабильным и процессуальным, а роль художника смещается от создания объекта к созданию условий, в которых развивается жизнь.
Рассмотренные кейсы — от генетически модифицированного кролика и выращенной ткани до биолюминесцентных микроорганизмов — показывают, насколько разнообразными могут быть формы взаимодействия искусства и биологии. Они демонстрируют, что жизнь в искусстве становится не только материалом, но и соавтором, влияющим на форму, поведение и смысл произведения.
Таким образом, биоарт открывает новое поле для осмысления границ творчества, авторства и ответственности. Он заставляет переосмыслить отношения человека с природой и технологией, поднимая вопросы о том, что значит создавать, изменять или поддерживать жизнь. Именно в этом пересечении биологии, искусства и философии проявляется ключевая ценность биоарта — его способность формировать новые способы видеть, чувствовать и понимать живые процессы в мире, где границы между живым и искусственным становятся всё более размытыми.
Myers, W. (2015). Bio Art: Altered Realities. Thames & Hudson.
Bio-Art: when life itself is the creative medium [Электронный ресурс]. — Режим доступа: https://neomaniamagazine.com/bio-art/ (дата обращения: 19.11.2025).
Trends in Biotechnology [Электронный ресурс]. — Режим доступа: https://www.sciencedirect.com/science/article/abs/pii/S016777991500205X (дата обращения: 19.11.2025).
EDUARDO KAC [Электронный ресурс]. — Режим доступа: https://ekac.org/ivam.show.nglsh.html (дата обращения: 19.11.2025).
Bio-art: The ethics behind the aesthetics [Электронный ресурс]. — Режим доступа: https://www.researchgate.net/publication/26246108_Bio-art_The_ethics_behind_the_aesthetics (дата обращения: 19.11.2025).
GFP Bunny [Электронный ресурс]. — Режим доступа: https://www.ekac.org/gfpbunny.html (дата обращения: 19.11.2025).
Victimless Leather (2004) [Электронный ресурс]. — Режим доступа: https://www.fact.co.uk/artwork/victimless-leather-2004 (дата обращения: 19.11.2025).
Свет океана или биолюминесцентная лампа от Терезы ван Доген [Электронный ресурс]. — Режим доступа: https://lightstar.ru/blog/articles/svet-okeana-ili-bioljuminestsentnaja-lampa-ot-terezy-van-dogen (дата обращения: 19.11.2025).
Bio Art — Facilities — BFA Fine Arts — School of Visual Arts, SVA NYC [Электронный ресурс]. — Режим доступа: https://bfafinearts.sva.edu/facility/bio-art/ (дата обращения: 19.11.2025).
BioArt Laboratories [Электронный ресурс]. — Режим доступа: https://bioartlab.com/ (дата обращения: 19.11.2025).
Стволовые клетки [Электронный ресурс]. — Режим доступа: https://www.lunifera.ru/blog/stvolovie-kletki-v-kosmetike/?srsltid=AfmBOoryDEtvkP04fO-pvHSbFvo32lyG9YNvHy7rmrRF81HTJT66wrXU (дата обращения: 19.11.2025).
Нейральные стволовые клетки [Электронный ресурс]. — Режим доступа: https://elementy.ru/kartinka_dnya/1271/Neyralnye_stvolovye_kletki (дата обращения: 19.11.2025).
БАКТЕРИИ СОЗДАЮТ СЕТИ ВЗАИМОПОМОЩИ И ПОДКАРМЛИВАЮТ ДРУГ ДРУГА Информация взята с портала «Научная Россия» [Электронный ресурс]. — Режим доступа: https://scientificrussia.ru/articles/bakterii-podkarmlivaiut-drug-druga (дата обращения: 19.11.2025).
Движение бактерий [Электронный ресурс]. — Режим доступа: https://biomolecula.ru/articles/dvizhenie-bakterii (дата обращения: 19.11.2025).
Бактерии [Электронный ресурс]. — Режим https://winzoro.net/2012/04/17/bakterii.html (дата обращения: 19.11.2025).
Рост бактерий в чашках Петри [Электронный ресурс]. — Режим доступа: https://lori.ru/7547184 (дата обращения: 19.11.2025).
Компания Light Bio выпустила в свободную продажу светящиеся домашние растения [Электронный ресурс]. — Режим доступа: https://www.techcult.ru/science/13387-kompaniya-light-bio (дата обращения: 19.11.2025).
Microvenus — арт-объект, созданный с помощью генной инженерии, или как заставить символ «жить»? [Электронный ресурс]. — Режим доступа: https://biomolecula.ru/articles/microvenus-art-obekt-sozdannyi-s-pomoshchiu-gennoi-inzhenerii-ili-kak-zastavit-simvol-zhit (дата обращения: 19.11.2025).
Anicka Yi «Biologizing the Machine» «Terra Incognita» «Tentacular Trouble» Venice Biennale International Art Exhibition [Электронный ресурс]. — Режим доступа: https://www.visit-venice-italy.com/biennale-venice/2019/anicka-yi-venice-biennale-art.html (дата обращения: 19.11.2025).
Светящийся кролик: как искусство соединяется с наукой [Электронный ресурс]. — Режим доступа: honline.ru/tpost/tigt23yfk1-svetyaschiisya-krolik-kak-iskusstvo-soed (дата обращения: 19.11.2025).
Краткая история зелёного флуоресцентного белка [Электронный ресурс]. — Режим доступа: https://habr.com/ru/articles/914684/ (дата обращения: 19.11.2025).
Some Survive, Few Are Conserved, Even Fewer Can Travel: Paradoxes and Obstacles in Maintaining and Staging Biomedia Art [Электронный ресурс]. — Режим доступа: https://www.getty.edu/publications/living-matter/snapshots/06/ (дата обращения: 19.11.2025).
Museum Kills Live Exhibit [Электронный ресурс]. — Режим доступа: https://www.getty.edu/publications/living-matter/snapshots/06/ (дата обращения: 19.11.2025).
Leather jacket grows in dish [Электронный ресурс]. — Режим доступа: https://www.abc.net.au/science/news/stories/s1346077.htm (дата обращения: 19.11.2025).
Биолюминесценция [Электронный ресурс]. — Режим доступа: https://pikabu.ru/story/biolyuminestsentsiyabioluminescence_7465361 (дата обращения: 19.11.2025).
Что такое биолюминесценция? [Электронный ресурс]. — Режим доступа: https://far-light.ru/mediacenter/detail/?ID=1536 (дата обращения: 19.11.2025).
Ambio [Электронный ресурс]. — Режим доступа: https://www.teresavandongen.com/filter/light/Ambio (дата обращения: 19.11.2025).




